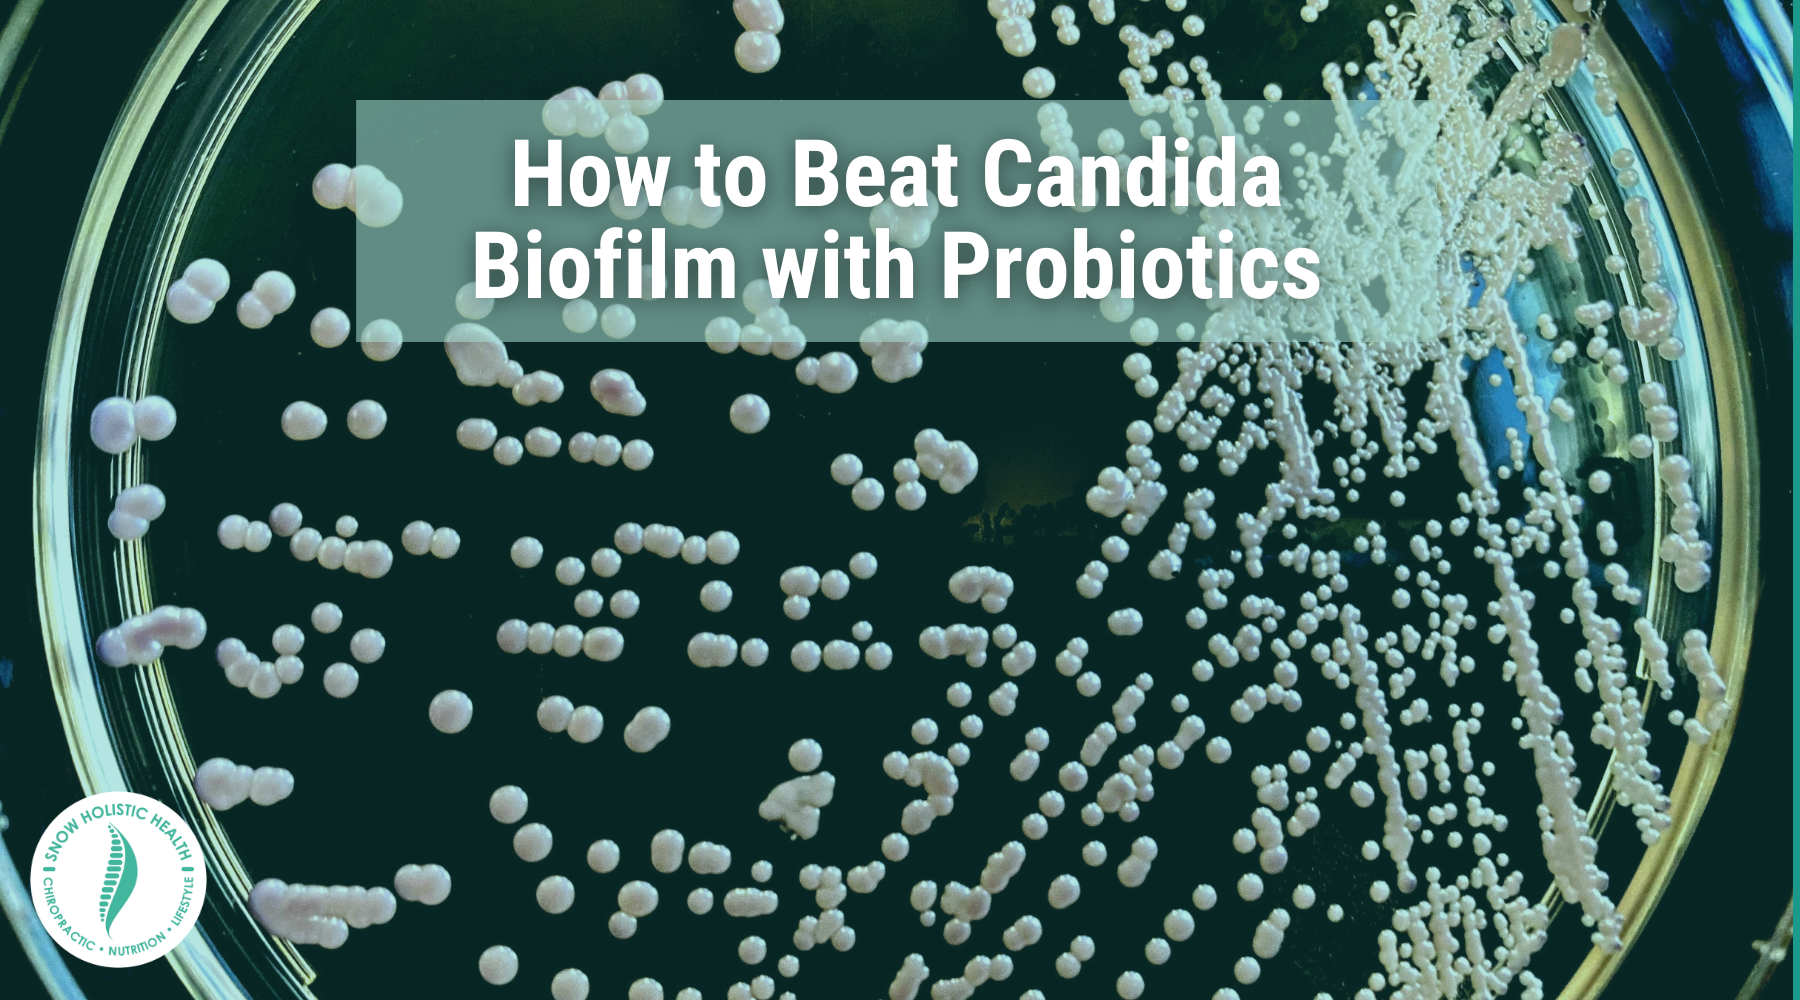
How to Beat Candida Biofilm with Probiotics over petri dish with candida

How to Test for Candida Overgrowth in the Gut?: Top 5 Candida FAQ
How can you test for candida overgrowth in the gut? Does candida cause bloating? What herbs kill candida? In this article, we’ll explore the five most frequently asked questions about candida overgrowth.

Dr. Eric Snow's Gut Rescue vs. Ancient Nutrition Candida Balance
In this article, we examine two popular candida cleanse supplements: Dr. Eric Snow’s Gut Rescue vs. Ancient Nutrition Candida Balance.

Oregano Oil for Candida
Introducing: oregano oil. This potent anti-microbial, anti-fungal herbal oil is an easy-to-use candida cleanse agent that can help you heal your microbiome from candida overgrowth. In this article, we explore how to use oregano oil for candida.

Can Candida Cause Weight Gain?
Can candida cause weight gain? In this article, we’ll explore how candida overgrowth impacts weight gain, and what you can do to stop it.

4 Best Oregano Supplement Health Benefits
How to Beat Candida Biofilm with Probiotics
When our gut's microbiome is out of balance, it can cause serious issues with our digestion and general wellbeing. Candida overgrowth is a common form of microbiome imbalance that can impact our health. Keep reading to learn more about Candida biofilms and the best probiotics for Candida overgrowth.

